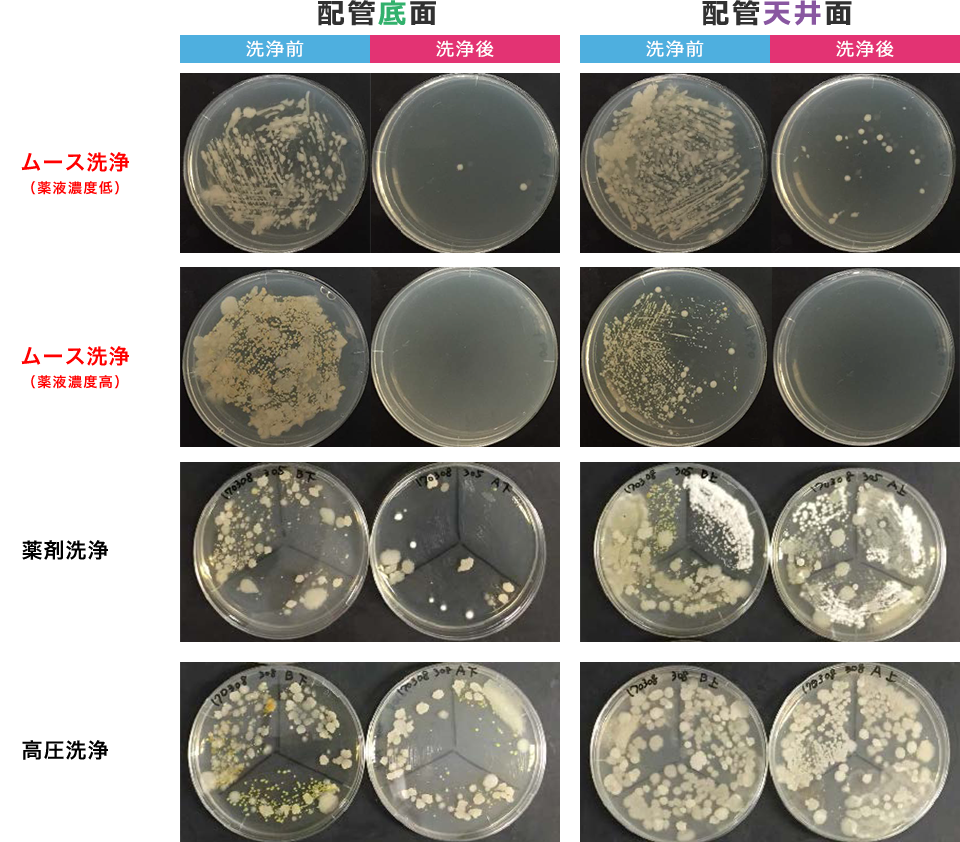

低圧ムース洗浄機(特許取得工法)
加盟店募集
水環境、健康について積極的に改善するべく意欲のある法人、個人の方を、全国で施工店を募集しております。独立・開業を当社が全面的にバックアップいたします。

「低圧ムース洗浄工法」とは、築30年を越えるマンション等の老朽化した排水管を水漏れなく洗浄できる、環境アコロ社が独自開発した特許取得洗浄工法です。
マンション、団地、ホテル、公的施設等の排水管に低圧ムースの泡のみを注入し管内壁面に高密度の泡が隅々まで届き留まり効率よく洗浄します。
従来の高圧洗浄工法では老朽化した排水管を傷めてしまい、水漏れのリスクや細く曲がりくねった排水管では洗浄が不可能でした。その問題を解決出来るのが低圧ムース洗浄工法です。



マンション等の排水管の洗浄は、旋回ジェットムース洗浄車により低圧ムースの泡を各排水口より注入をしてカビ・害虫・バイ菌等の汚れを化学的に分解する洗浄方法です。
また、大規模のマンションや建物では洗浄水を最終のマンホールより洗浄水調整車にてPH調整を行い放流を致します。
低圧ムース洗浄カートタイプ式は機動性と簡易的な洗浄作業の場所に向いています。
高層階のマンションや大規模な建物内での施工に大活躍の装置です。
時間指定される入居者様より好評です。
入居者様のストレスフリーな画期的洗浄機!
 24Lタンク
24Lタンク
 50Lタンク
50Lタンク
●マンション施工中

●液体洗浄剤の場合


●ムース状洗浄剤の場合

●液体洗浄剤の場合


●ムース状洗浄剤の場合

洗浄イメージ写真 ※わかりやすくするために着色しています。
従来の排水管洗浄液剤では液体の為すぐに流れてしまい排水管の上部に薬液が届きませんでした。
その問題を解決したのが排水管洗浄液を低圧ムースの泡にした事で排水管の上部に薬品の泡が届き留まり長時間に渡り洗浄が可能です。
また、直径わずか1/1000mmのきめ細やかなムース状の泡を、管内に立体的に長時間、効果的に洗浄清掃を致します。






排水管洗浄液を圧縮空気で薬液を低圧のムースにする事により泡の体積が約20倍に増え、少ない排水管洗浄液での洗浄施工が可能になりました。
よって排水管洗浄液の量を1/20と極めて少量に抑えられ、薬液の入った洗浄水を水道水のみの希釈で放流できる環境へも配慮した特許技術工法です。
また、ムースの泡が汚れに浸透し洗浄効果を最大限に引き出します。



| 洗浄工法 | 施工比較 | 洗浄作用 | 安全性 | 殺菌効果 | 保証 | 施工費 | 特許権利 取得会社 |
総合評価 |
|---|---|---|---|---|---|---|---|---|
|
低圧ムース 薬液を高密度な泡にして科学的に汚れを分解洗浄する工法 |
低圧ムースが管内に届き留まり物理的、化学的に消毒洗浄を致します。 |
物理的、化学的塩基作用 |
低圧ムースのみを注入するので安全です。 |
化学的に洗浄するので殺菌消臭効果あり。 |
|
ムース状の泡が管内に届き留まり施工時間が短縮され、安い。 |
アコロテックジャパン株式会社 |
マンション等の定期排水管洗浄に向いている。 |
|
低圧ムース ナイロンノズルを用いた物理的、薬品の化学的な洗浄方法 |
回転ノズルを排水管内に入れて旋回しながら洗浄、ムースの泡が物理的、化学的に消毒洗浄を致します。 |
物理的、化学的塩基作用 |
ムースを噴射させるので管内にかかる圧力が弱いので安全。 |
排水管洗浄剤による化学的な洗浄なので殺菌効果あり。 |
|
ノズルを入れる為、時間は掛かるが高圧洗浄より効果的で安い。 |
アコロテックジャパン株式会社 |
マンション等の定期排水管洗浄清掃に効果的で向いている。 |
|
高圧 高圧水による物理的な水圧のみで、異物を除去する洗浄方法 |
逆噴射ノズルを管内に入れる為、小径または曲がりの多い管は洗浄不可。また、洗浄ワイヤーで管内を痛め水漏れの心配あり。 |
物理的水圧作用 |
高圧水で洗浄する為、水漏れの恐れあり。 |
物理的な水圧洗浄なので特に効果はない。 |
なし |
ノズルを入れる為、時間がかかり施工効果、施工費の割に高い。 |
該当なし |
定期排水管清掃に向いていない。詰り除去用 |
キッチンの排水口より洗浄ノズルを投入し、先端のナイロンノズルだけ回転させます。遠心力によりカッターナイフのように汚れだけを細かく砕きます。

当社は日本で初めて排水管の洗浄方法にムースの泡を採用し特許取得をしている会社です。
世界特許取得 2017年 8月27日
日本特許取得 2014年12月19日
大手製薬会社の泡スプレー『バブルーン』
発売日 2019年8月20日より販売開始
当社の方が5年も早い時期からムースの泡による排水管の洗浄施工をしています。
群馬大学機器分析センター 林史夫
群馬大学と共同で、「複数の洗浄工法でどのような違いが出るのか明らかにすること」を目的として、「1.処理位置から離れたところでの洗浄効果」と「2.配管内の通常液体が流れにくい天井面での洗浄効果」の2点を調査・比較する配管洗浄試験を3回にわたって行いました。洗浄前と洗浄後の配管内サンプリングを培養したものを比較する検証も実施しました。
下の写真からも一目瞭然のように、薬剤洗浄・高圧洗浄に比べて「低圧ムース洗浄と、適切な洗剤・薬剤を選択した低圧ムース洗浄工法は、生物的な洗浄において従来の洗浄方法よりも有効である」という結果が得られました。

| ※低圧ムース洗浄施工の場合 |
|---|
| ■塩化ビニール素材の配管 |
| ※築50年未満(保証付き) |
| ※築50年以上(保証無し) |
| ■白鋼管、鋳物製素材の配管 |
| ※築40年未満(保証付き) |
| ※築40年以上(保証無し) |
■白鋼管30年 ■塩ビ管30年(VP,VU,VM,HIVP) ■鋳鉄管40年
●注意事項
日常的に漂白剤(次亜塩素酸ナトリウム)を殺菌、漂白目的で使用されている場合白鋼管、鋳物製の配管は酸化し錆びるのを促進してしまうので保証外となる場合があります。
『ムースブレイド洗浄工法』施工による塩化ビニール、白鋼管、鋳物製素材の配管の洗浄に付いては、従来の高圧洗浄工法より配管の破損、水漏れをおこすリスクが極限に軽減回避出来る画期的な洗浄技術です。
ムースブレイド洗浄にて汚れを取り除いた後に水漏れをした場合は経年劣化による配管の寿命ですので水漏れに伴う工事代金は上記(保証付き)以外は別途費用となります。
以上、上記の内容をご確認の上、ご発注いただきますようお願い申し上げます。